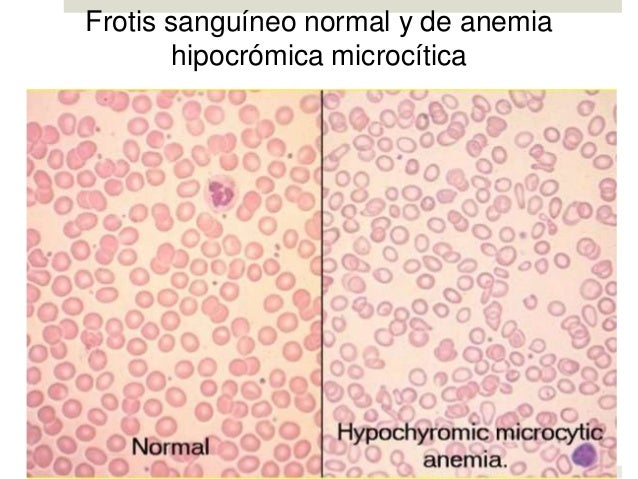

1. ANEMIA MICROCÍTICA HIPOCRÓMICA
Aumento: 100X
Tinción: Wright
Descripción: Se manifiesta por
un VCM menor de 80 fL y una CHbCM menor de 32g/dL, con células pequeñas que
tienen aumento de la palidez central en el extendido. Las anemias microcíticas
por lo general son consecuencia de una anomalía de la síntesis de Hb, ferropenia,
deficiencia de la síntesis del hierro hemo, talasemias y enfermedades crónicas.
(Carr, 2010)
URL de la imagen:
http://www.elmedicointeractivo.com/ap1/emiold/aula2001/tema1/anemia4.php
2. ANEMIA NORMOCÍTICA
NORMOCRÓMICA
Aumento: 40X
Tinción: Wright
Descripción: El VCM es de
80-94 fL, HbCM de 27 a 32 pg y la CHbCM de 32 a 36 g/dL (%). Las anemias
normocíticas son causadas por lo general son causadas por hemólisis,
hemorragias agudas, tumores malignos (leucemia, linfoma, carcinoma),
esplenomegalia (los eritrocitos son atrapados y destruidos en el bazo), agentes
tóxicos, enfermedades crónicas, infecciones, artritis reumatoidea y
enfermedades renales y hepáticas. (Carr,
2010)

URL de la imagen:
http://www.probiomed.com.mx/divisiones/art-culos-de-alta-especialidad/a/metabolismo-del-hierro-y-anemia-secundaria-a-insuficiencia-renal-cr-nica
3. ANEMIA MACROCÍTICA
MEGALOBLASTICA
Aumento: 40X
Tinción: Wright
Descripción: Las anemias
megaloblásticas por lo general se producen por deficiencia de vitamina B12 o de
folato. Este tipo de anemia se caracteriza por la presencia de macrocitos ovalados u células en forma de lágrima en
sangre periférica y de megaloblastos o precursores de eritrocitos nucleados
grandes en la médula ósea. También se caracteriza por la presencia de
eritrocitos grandes, que son redondos en su mayor parte, pero los nucleados
presentes en la médula ósea no muestran alteraciones megaloblásticas de
maduración. (Carr, 2010)

URL de la imagen:
http://spongetasticallyfamo.wix.com/propel
4. ANEMIA MACROCÍTICA SIN
MEGALOBLASTOSIS
Aumento: 100X
Tinción: Wright
Descripción: Presencia de
reticulocitos altos en casos de anemia hemolítica o post-hemorrágica. La
severidad de la anemia y el grado de macrocitosis dependen de la severidad y la
duración de la carencia. (Manascero,
2003)

URL de la imagen:
http://www.lookfordiagnosis.com/mesh_info.php?term=Anemia+Macroc%C3%ADtica&lang=2
5. ANEMIA FERROPRIVA
Aumento:100X
Tinción:Wrigth
Anemia microcítica hipocrómica
secundaria a carencia de hierro necesario para la síntesis de hemoglobina.
En este tipo de anemia los
glóbulos rojos aparecen normocíticos normocrómicos, pero en número reducido. (Rodak, 2005)

URL de imagen:
http://labbcbtis7.blogspot.com/2013/04/biometriahematica-hemoglobina-la.html
6. ANEMIA HEMOLÍTICA
Tinción:Wrigth
Afección en la cual hay un
número insuficiente de glóbulos rojos en la sangre, debido a su destrucción prematura.
Se produce cuando el sistema
inmunitario erróneamente toma a sus propios glóbulos rojos como sustancias
extrañas. Entonces se desarrollan anticuerpos contra estos glóbulos
rojos. En esta degradación se observan abundantes crenocitos. (Risso, 2014)

URL Imagen: http://encuentratodo2-m3.blogspot.com/2009/03/alteraciones-de-globulos-rojos.html
7. ANEMIA DE CÉLULAS FALCIFORMES
Aumento:100X
Tinción:Wrigth
Enfermedad en la que su cuerpo
produce glóbulos rojos con un contorno anormal.
Los eritrocitos producen
hemoglobina anormal, esto hace que los eritrocitos adquieran una forma de
medialuna u hoz.
Las células falciformes son
rígidas y pegajosas; tienden a obstruir la circulación de la sangre por los
vasos sanguíneos de las extremidades y los órganos. (Carr, 2010)

Url de Imagen:
http://www.lookfordiagnosis.com/mesh_info.php?term=Anemia+de+C%C3%A9lulas+Falciformes&lang=2
8. HEMOGLOBINOPATÍA S
Aumento:100X
Tinción:Wrigth
Causada por un tipo anormal de
hemoglobina llamada hemoglobina S, la cual presenta una alteración de la
estructura de la globina cambiando la forma de los eritrocitos.
Se observa la presencia de
drepanocitos.
Las células anormales llevan
menos oxígeno a los tejidos corporales.Igualmente se pueden atorar más
fácilmente en pequeños vasos sanguíneos y romperse en pedazos. (Manascero,
2003)

Url de Imagen:
http://cientificosenfurecidos.blogspot.com/2014_08_01_archive.html
9. HEMOGLOBINOPATÍA E
Aumento: 100X
Tinción: Wright
Variante de la cadena beta en
la que la lisina sustituye al acido glutámico en la posocion 26.
Se observa una anemia leve con
microcitos y células blanco. (Rodak, 2005)
URL de la imagen:
http://books.google.com.gt/books?id=rFqhpbKnWX8C&pg=PA323&dq=hemoglobinopatia+E&hl=es&sa=X&ei=pH1VVKmjFcuqNvTEg4gI&ved=0CDgQ6AEwBQ#v=onepage&q=hemoglobinopatia%20E&f=false
10. TALASEMIA MAYOR
Aumento: 100X
Tinción: Wright
Trastorno hereditario
caracterizado por la producción defectuosa de hemoglobina que lleva a una
disminución en la producción y un aumento de la destrucción de los glóbulos
rojos.La hemoglobina contiene dos cadenas, la globina alfa y beta.
La talasemia mayor es la forma
más severa de anemia. Se caracterizada por anomalías en la producción de los
glóbulos rojos sanguíneos (hemoglobina).
Se pueden observar eritrocitos de
forma anormal, pálidos (hipocrómicos) y pequeños asociados con esta enfermedad. (Risso, 2014)
URL: https://www.google.com.gt/search?q=anemia+microcitica+hipocromica&biw=1137&bih=741&source=lnms&tbm=isch&sa=X&sqi=2&ved=0CAYQ_AUoAWoVChMI58G5jKyRyQIVQzMmCh2HAAXh&dpr=0.9#tbm=isch&q=talasemia+mayor+frotis&imgrc=WHbHkTsozd5oEM%3A
11. TALASEMIA MENOR
Tipo hereditario de anemia
hemolítica menos severo que la talasanemia mayor.
Se observan glóbulos rojos
sanguíneos de varias formas (poiquilocitosis), pálidos (hipocrómicos) y
pequeños (microcíticos), los cuales tienen menor capacidad para transportar el
oxígeno que los glóbulos rojos sanguíneos normales. (White,
2012)

URL: https://www.google.com.gt/search?q=anemia+microcitica+hipocromica&biw=1137&bih=741&source=lnms&tbm=isch&sa=X&sqi=2&ved=0CAYQ_AUoAWoVChMI58G5jKyRyQIVQzMmCh2HAAXh&dpr=0.9#tbm=isch&q=talasemia+mENOR+frotis&imgrc=PgVKxngXIVosjM%3A
12. LEUCEMIA
MIELOIDE AGUDA
Tipo de cáncer producido en las células de la
línea mieloide de los leucocitos, caracterizado por la rápida
proliferación de células anormales que se acumulan en la médula
ósea e interfieren en la producción de glóbulos rojos normales.
Tipo de leucemia aguda más común en adultos y
su incidencia aumenta con la edad. (Manascero, 2003)
![]() |
| Tabla de la Clasificación de las Leucemias Mieloides Agudas |
13. LEUCEMIA MIELOIDE CRÓNICA
Se considera un trastorno
mieloproliferativo crónico ; se caracteriza por panmielosis con predominio del
componente mieloide en la médula ósea, sangre periférica y otros órganos.
Se expresa la translocación
cromosómica t (9; 22) que da lugar a la formación del cromosoma Filadelfia
(Ph).
Coloración: Wright
Descripción:
Hay presencia de anemia,
leucocitosis marcada (50-500 x109/L o mayor), trombocitosis, eosinofilia,
basofília y un espectro de maduración de granulocitos con predominio de
mielocitos en sangre periférica.
Los mieloblastos constituyen
menos del 10% de los leucocitos circulantes.
En ocasiones se observan
eritrocitos nucleados.
La granularidad de las células
puede ser bastante variable, oscila desde un aspecto similar a la granulación
tóxica hasta microgranular; suele ser difícil diferenciar entre basófilos y
promielocitos anormales. (Carr, 2010)

URL: https://www.google.com.gt/search?q=anemia+microcitica+hipocromica&biw=1137&bih=741&source=lnms&tbm=isch&sa=X&sqi=2&ved=0CAYQ_AUoAWoVChMI58G5jKyRyQIVQzMmCh2HAAXh&dpr=0.9#tbm=isch&q=leucemia+mieloide+cronica&imgrc=NnSUMHZYCdncxM%3A
14. LEUCEMIA LINFOIDE AGUDA
Comprende un grupo
de neoplasias malignas que afectan los precursores (blastos) de
los linfocitos en la médula ósea.
La mayoría
son tumores de células progenitoras pre-B aunque
ocasionalmente se manifiestan LLA de células pre-T.
La LLA ocurre con gran
frecuencia en la primera década de vida, aumentando de nuevo el riesgo en la
edad madura. (Rodak, 2005)

15. LEUCEMIA LINFOCÍTICA CRÓNICA
Caracterizada por la
proliferación y acumulación de linfocitos inmunocompetentes de pequeño tamaño y
aspecto maduro en la sangre, la médula ósea y los tejidos linfáticos, con
fenotipo B en el 98% de los casos.
Su etiología es desconocida;
aunque podrían haber factores hereditarios asociados
Se observa linfocitosis
superior al 70%, citomorfológicamente anormal, con maduración anormal del
núcleo. (Carr, 2010)

URL: recuperada de
http://books.google.com.gt/books?id=apSP3g_oXNoC&pg=PA123&dq=leucemia+linfocitica+cronica&hl=es&sa=X&ei=tCpVVPq9EYueNrbogcAB&redir_esc=y#v=onepage&q=leucemia%20linfocitica%20cronica&f=false
16. LEUCEMIA DE CÉLULAS PILOSAS
Aumento: 100x
Tinción: Wright
Enfermedad linfoproliferativa
que se origina en los linfocitos B.
Las células leucémicas se
caracterizan por tener prolongaciones en el citoplasma “pelos”, una cromatina
finamente granular, núcleos reniformes u ovalados; además poseen fosfatasa
ácida positiva y resistente al tartrato.
La médula ósea suele presentar
infiltración por parte de las células pilosas, y fibrosis en grado variable. (Carr, 2010)
URL: recuperada de
http://books.google.com.gt/books?id=6ptpJtl80UwC&pg=PA166&dq=leucemia+de+celulas+peludas&hl=es&sa=X&ei=XDVVVO3hBcqkNu_lgogL&redir_esc=y#v=onepage&q=leucemia%20de%20celulas%20peludas&f=false

El cáncer colorrectal, cáncer del intestino grueso, es el cuarto cáncer más común en América del Norte. muchos casos de cáncer colorrectal están asociados con niveles bajos de actividad física y con dietas bajas en frutas y verduras. las personas con antecedentes familiares de la enfermedad tienen un mayor riesgo. me derrumbé con esta enfermedad durante 5 años también con muchos pensamientos aterradores en mi cabeza porque estaba esperando la muerte todos los días de mi vida hasta que mi hijo vino a mí en el hospital y me explicó que había encontrado un curandero de hierbas en Nigeria para curar mi cáncer colorrectal, estaba tan sorprendido con el ideal y también estaba emocionado dentro de mí. Mi hijo me pidió que le permitiera probarlo porque realmente hemos escuchado a un montón de estafadores pretendiendo curar todo tipo de enfermedades con medicamentos a base de hierbas y algunas de ellas nunca obtienen un resultado positivo al final de todo, pero teníamos mucha confianza en este médico a base de hierbas, como dije, le dimos una oportunidad y me envió un medicamento a base de hierbas para beber durante tres semanas. Sinceramente les digo que hoy estoy vivo y sano, no más acostado en la cama de enfermo, no más cáncer colorrectal. Estoy compartiendo este testimonio aquí para que las personas que están enfermas se comuniquen con este hombre maravilloso, su nombre es dr itua .y su contacto whatsapp_+2348149277967____email_drituaherbalcenter@gmail.com. sitio web: www.drituaherbalcenter.com él puede curar enfermedades como: cáncer de vejiga cáncer de mama cáncer colorrectal cáncer de riñón leucemia cáncer de pulmón linfoma no hodgkin cáncer de próstata cáncer de piel cáncer de útero vih / sida accidente cerebrovascular herpes hepatitis hechizo de amor diabetes
ResponderEliminar